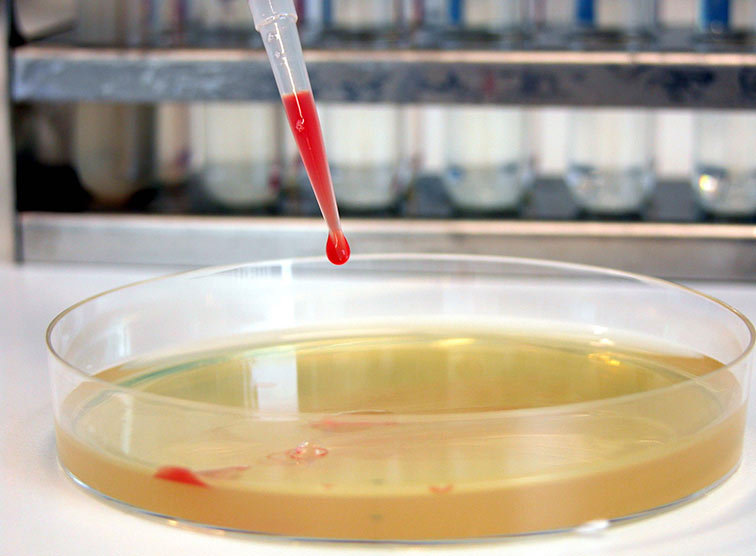

Merckens: "Wer tatsächlich möchte, dass ein Kompromiss hält, muss sicherstellen, dass dieser der Prüfung und daher der Logik der Höchstgerichte standhält."
Fortpflanzung: Höchstgericht-taugliche Formulierung gefordert
Bioethikkommission-Mitglied Merckens in der "Presse": Beschränkung der Genuntersuchung auf die Eizelle würde als nächstes kippen - Urteil zur Fremdkindadoption durch Homosexuelle Folge juristischer Versäumnisse
Mehrere Punkte der derzeitigen Fassung der Fortpflanzungsmedizingesetz-Novelle, über die der Nationalrat am Mittwoch entscheiden soll, widersprechen der Verfassung und dürften im Falle eines Beschlusses schon in absehbarer Zeit erneut vom Höchstgericht gekippt werden: Darauf hat Stephanie Merckens vom Institut für Ehe und Familie der Bischofskonferenz am Montag in einem "Presse"-Gastkommentar hingewiesen. Die Juristin, die auch Mitglied der Bioethikkommission ist, bezeichnete das Gesetz als heikel, da es gesellschaftliche Grundentscheidungen vornehme und durch seine Formulierungen die Weichen für weitere Urteile stelle. Merckens: "Die Krux und damit die Aufhebung durch die Höchstgerichte liegt im Detail."
Widerspruch im Gesetzestext
Konkret wies Merckens auf das Problem der von der Novelle erlaubten Präimplantationsdiagnostik und dessen Regelungen hin: Der Gesetzestext nehme bei der direkten Untersuchung am Embryo zwar eine sogar relativ strenge Beschränkung vor, "absurderweise" jedoch überhaupt keine Beschränkungen für die indirekte Genuntersuchung am sogenannten "Polkörper" der Eizelle. Genetische Erbkrankheiten mütterlicherseits - und zwar auch nicht schwerwiegende - dürften somit festgestellt werden, nicht jedoch seitens des Vaters, was ein Widerspruch sei. "Die nächste Korrektur durch Höchstgerichte ist schon absehbar", so die Juristin.
Bei beiden Formen der Genuntersuchungen seien die Folgen gleich, warnte Merckens, "für die betroffenen und zumeist auch für die überflüssigen Embryonen ist Endstation". Die Expertin plädierte dafür, beide Untersuchungsformen juristisch gleich zu behandeln, wofür sich auch die Bioethikkommission einstimmig ausgesprochen habe. Zuwider laufen würde eine derartige Vorgangsweise einzig dem Interesse der Anbieter der Polkörperdiagnostik.
Absehbare Logik
In ihrem Beitrag zog Merckens auch einen Bezug zur jüngsten höchstgerichtlichen Aufhebung der Fremdkindadoption durch Homosexuelle: Der Entscheid sei im Grunde zu erwarten gewesen, "nicht, weil es juristisch keine andere Entscheidungsmöglichkeit gegeben hätte, sondern weil er im Geiste der bisherigen Wertung der Argumente liegt", so Merckens. Die Weichen dazu seien bei der Einführung der eingetragenen Partnerschaft gestellt worden, als Befürchtungen der Kritiker der Homo-Ehe, Homo-Elternschaft oder auch Leihmutterschaft noch als Schwarzmalerei abgetan worden seien.
Juristisch sei damals eine Logik gewählt worden, die "einer von einigen Interessensgruppen offen geäußerten Absicht" gefolgt sei, so Merckens - indem etwa in der Ausformulierung zu wenig explizit dargelegt worden sei, "dass die Verbindung zweier Männer bzw. zweier Frauen eben nicht das Gleiche ist wie jene von Mann und Frau". Verabsäumt worden sei auch die Rechtfertigung einer unterschiedlichen Behandlung "durch die Tatsache, dass die Stiefkindadoption eine De-facto-Situation rechtlich absichert, bei der Fremdkindadoption aber ein Kind überhaupt erst neu in eine De-facto-Situation kommt".
Dem Verfassungsgerichtshof warf die Juristin vor, somit mit der Wertung der Argumente Politik zu machen. Da dies jedoch durchaus abzusehen gewesen sei, liege die Verantwortung für nachhaltige Gestaltung der Gesetze dann doch wieder beim Parlament und bei den Regierungsparteien. Merckens: "Wer tatsächlich möchte, dass ein Kompromiss hält, muss sicherstellen, dass dieser der Prüfung und daher der Logik der Höchstgerichte standhält."
» Gutachten des IMABE-Instituts
» Interview mit Kardinal Schönborn
» Kampagne kinderbekommen.at
» Homepage "aktion leben"
» Betroffenen-Site der Lebenskonferenz




































































































